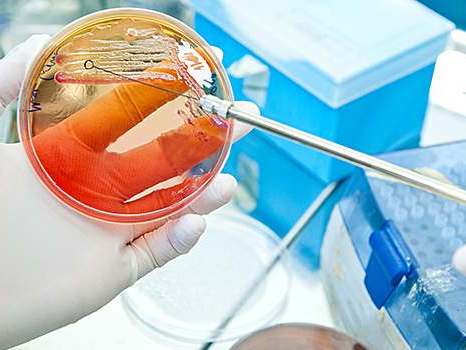

| 产品名称:Orflo品牌Moxi Z迷你自动细胞计数仪及芯片和MOXIFLOW流式细胞仪及芯片 | ||||||||||
| 品牌:美国 | ||||||||||
| 货号:Orflo | ||||||||||
| 价格:询价 | ||||||||||
| 联系人:李经理 | ||||||||||
| 电话:18618101725 | ||||||||||
kord-valmark叠放自动化培养皿与培养皿等现货促销kord-valmark自动化培养皿 自动化可滑动聚苯乙烯培养皿 可滑动盖子提供手动使用的半堆叠功能,同时确保在自动化设备中易用 自动化盖子没有边缘,确保在自动化设备中易用 可用于Side Arrows和/或ISO Mark Targets kord-valmark可堆叠培养皿和自动化用培养皿----quan系列现货Kord-Valmark 公司位于美国Sandusky市,从1968年以来一直专注于生产多种规格高质量平皿,实验室耗材和保健用品。其产品由晶体聚苯乙烯制作,晶莹透明不影响观察,比玻璃皿轻巧;在严格的洁净厂房中生产,辐射灭菌,wu菌包装,一次性使用方便、安经济;另有多分格细菌培养皿,适用于相同培养条件下多种培养基培养,更加方便经济;方形培养皿用于抗生素效价的测试。 Kord-Valmark以品质、专业服务在国内赢得了众多高校和科研院所的支持,现正在努力向来自球的客户提供更多化标准的产品和服务。 产品亮点:
产品介绍 1、普通用可堆叠培养皿 货号 规 格(mm) 包 装 2、自动化用培养皿 货号 规 格(mm) 包 装
|